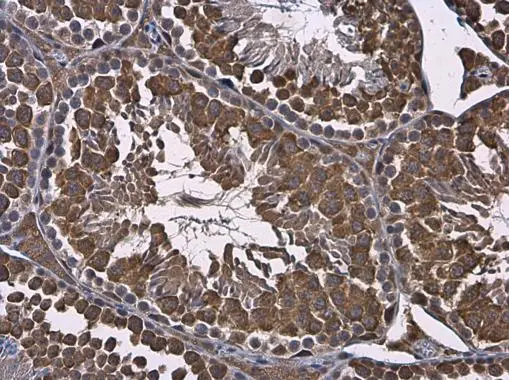
RUVBL1 antibody detects RUVBL1 protein at cytoplasm in mouse testis by immunohistochemical analysis. Sample: Paraffin-embedded mouse testis. RUVBL1 antibody (GTX111294) diluted at 1:500.
Antigen Retrieval: Citrate buffer, pH 6.0, 15 min RUVBL1 antibody detects RUVBL1 protein at cytoplasm in mouse testis by immunohistochemical analysis. Sample: Paraffin-embedded mouse testis. RUVBL1 antibody (GTX111294) diluted at 1:500.
Antigen Retrieval: Citrate buffer, pH 6.0, 15 min
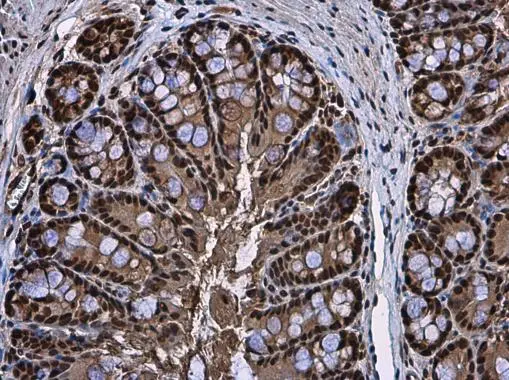
RUVBL1 antibody detects RUVBL1 protein at cytoplasm and nucleus in mouse colon by immunohistochemical analysis. Sample: Paraffin-embedded mouse colon. RUVBL1 antibody (GTX111294) diluted at 1:500.
Antigen Retrieval: Citrate buffer, pH 6.0, 15 min RUVBL1 antibody detects RUVBL1 protein at cytoplasm and nucleus in mouse colon by immunohistochemical analysis. Sample: Paraffin-embedded mouse colon. RUVBL1 antibody (GTX111294) diluted at 1:500.
Antigen Retrieval: Citrate buffer, pH 6.0, 15 min

Immunohistochemical analysis of paraffin-embedded human colon carcinoma, using RUVBL1(GTX111294) antibody at 1:500 dilution.
Antigen Retrieval: Trilogy? (EDTA based, pH 8.0) buffer, 15min
RUVBL1 antibody
GTX111294
ApplicationsImmunoFluorescence, ImmunoPrecipitation, Western Blot, ImmunoCytoChemistry, ImmunoHistoChemistry, ImmunoHistoChemistry Paraffin
Product group Antibodies
ReactivityHuman, Mouse, Rat
TargetRUVBL1
Overview
- SupplierGeneTex
- Product NameRUVBL1 antibody
- Delivery Days Customer9
- Application Supplier NoteWB: 1:500-1:3000. ICC/IF: 1:100-1:1000. IHC-P: 1:100-1:1000. IP: 1:100-1:500. *Optimal dilutions/concentrations should be determined by the researcher.Not tested in other applications.
- ApplicationsImmunoFluorescence, ImmunoPrecipitation, Western Blot, ImmunoCytoChemistry, ImmunoHistoChemistry, ImmunoHistoChemistry Paraffin
- CertificationResearch Use Only
- ClonalityPolyclonal
- Concentration0.32 mg/ml
- ConjugateUnconjugated
- Gene ID8607
- Target nameRUVBL1
- Target descriptionRuvB like AAA ATPase 1
- Target synonymsECP-54, ECP54, INO80H, NMP 238, NMP238, PONTIN, Pontin52, RVB1, TIH1, TIP49, TIP49A, ruvB-like 1, 49 kDa TATA box-binding protein-interacting protein, 49 kDa TBP-interacting protein, 54 kDa erythrocyte cytosolic protein, INO80 complex subunit H, RuvB (E coli homolog)-like 1, RuvB-like AAA ATPase, TAP54-alpha, TATA binding protein interacting protein 49 kDa, TIP60-associated protein 54-alpha, epididymis secretory sperm binding protein, nuclear matrix protein 238, pontin 52
- HostRabbit
- IsotypeIgG
- Protein IDQ9Y265
- Protein NameRuvB-like 1
- Scientific DescriptionPossesses single-stranded DNA-stimulated ATPase and ATP-dependent DNA helicase (3 to 5) activity. Component of the NuA4 histone acetyltransferase complex which is involved in transcriptional activation of select genes principally by acetylation of nucleosomal histones H4 and H2A. This modification may both alter nucleosome - DNA interactions and promote interaction of the modified histones with other proteins which positively regulate transcription. This complex may be required for the activation of transcriptional programs associated with oncogene and proto-oncogene mediated growth induction, tumor suppressor mediated growth arrest and replicative senescence, apoptosis, and DNA repair. The NuA4 complex ATPase and helicase activities seem to be, at least in part, contributed by the association of RUVBL1 and RUVBL2 with EP400. NuA4 may also play a direct role in DNA repair when recruited to sites of DNA damage. RUVBL1 plays an essential role in oncogenic transformation by MYC and also modulates transcriptional activation by the LEF1/TCF1-CTNNB1 complex. May be able to bind plasminogen at cell surface and enhance plasminogen activation. Essential for cell proliferation.
- ReactivityHuman, Mouse, Rat
- Storage Instruction-20°C or -80°C,2°C to 8°C
- UNSPSC12352203